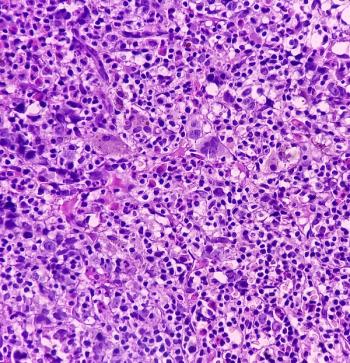

Lymphoma
Latest News
Latest Videos

CME Content
More News

The results show promise for the use of Bruton tyrosine kinase inhibitors in non-Hodgkin lymphoma treatment.

Patients exhibited improved disease-free progression with minimal adverse effects.

Zanubrutinib demonstrated sustained responses in patients with relapsed/refractory (R/R) chronic lymphocytic leukemia or small lymphocytic lymphoma (CLL/SLL).

Poorer prognosis was linked to factors such as reduced hemoglobin levels and advanced stage at diagnosis.

These results indicate the combination’s long-term effectiveness in a population with limited treatment options.

Improvements in survival outcomes were seen among those at high risk for DLBCL who received 6x R-CHOP21 + 2R.

Presenter Krish Patel, MD, discusses the use of epcoritamab (Epkinly; AbbVie) and glofitamab (Columvi; Genentech) in aggressive B-cell lymphomas as monotherapies and in combination regimens.

Experts debate over the most effective treatment pathway for Richter transformation, highlighting the risks and benefits of different cellular therapies.

Reid Merryman, MD, discusses the potential for minimal residual disease (MRD) to inform treatment decisions, identify lymphoma subgroups, and infer gene expression.

Surprisingly, those with overweight BMI at diagnosis did not have a poor prognosis.

Stefan Barta, MD, MS, MRCPCUK, discusses the potential role of biomarkers in predicting treatment outcomes, the emerging use of CAR T-cell therapy, and the benefits and challenges of combination therapies in managing T-cell lymphoma.

Sonali Smith, MD, discusses T-cell–directed therapies for indolent B-cell lymphoma, focusing on their efficacy, FDA-approved treatments, and treatment challenges, such as managing cytokine release syndrome.

Patients with DLBCL on Medicaid had worse survival outcomes than those on commercial insurance, but there were no statistically significant differences in survival between races.

In survivors of lymphoma with fragmented transition of care, preparedness and activation for the next phase of their survivorship was lacking.

The indication is for adults with relapsed or refractory chronic lymphocytic leukemia or small lymphocytic lymphoma who were treated with at least 2 prior lines of therapy.

Aligning with previous data, the drug combination was modestly effective in patients with large B-cell lymphoma pre- and post-CAR-T-cell therapy.

Bendamustine resulted in a greater risk of treatment complications in patients with lymphoma.

This article reviews the efficacy and safety data for bispecific T-cell engagers and the practical considerations for their implementation across various types of practice sites for the historically difficult-to-treat relapsed/refractory B-cell lymphoma population.

Building off the positive results of ELM-1, the ELM-2 trial found intravenously administered odronextamab was safe and effective in patients with relapsed or refractory follicular lymphoma.

The data builds off prior studies supporting bendamustine-rituximab as a first-line treatment for patients with non-Hodgkin lymphoma.

Pharmacists will play an integral role in this evolving field, from patient education and monitoring AEs to new therapeutic developments and treatment protocols.

A variety of signs and symptoms of lymphoma were reported, including fever, stomach discomfort, and weight loss.

Denileukin diftitox-cxdl is the only therapy approved for cutaneous T-cell lymphoma that targets IL-2 receptors in malignant T-cells and Tregs.

Replacing carmustine with cisplatin in BEAM ((carmustine, etoposide, cytarabine, and melphalan) conditioning could be more cost-effective for patients.
Investigators determine the efficacy and safety of the combination in a 2-phase trial.